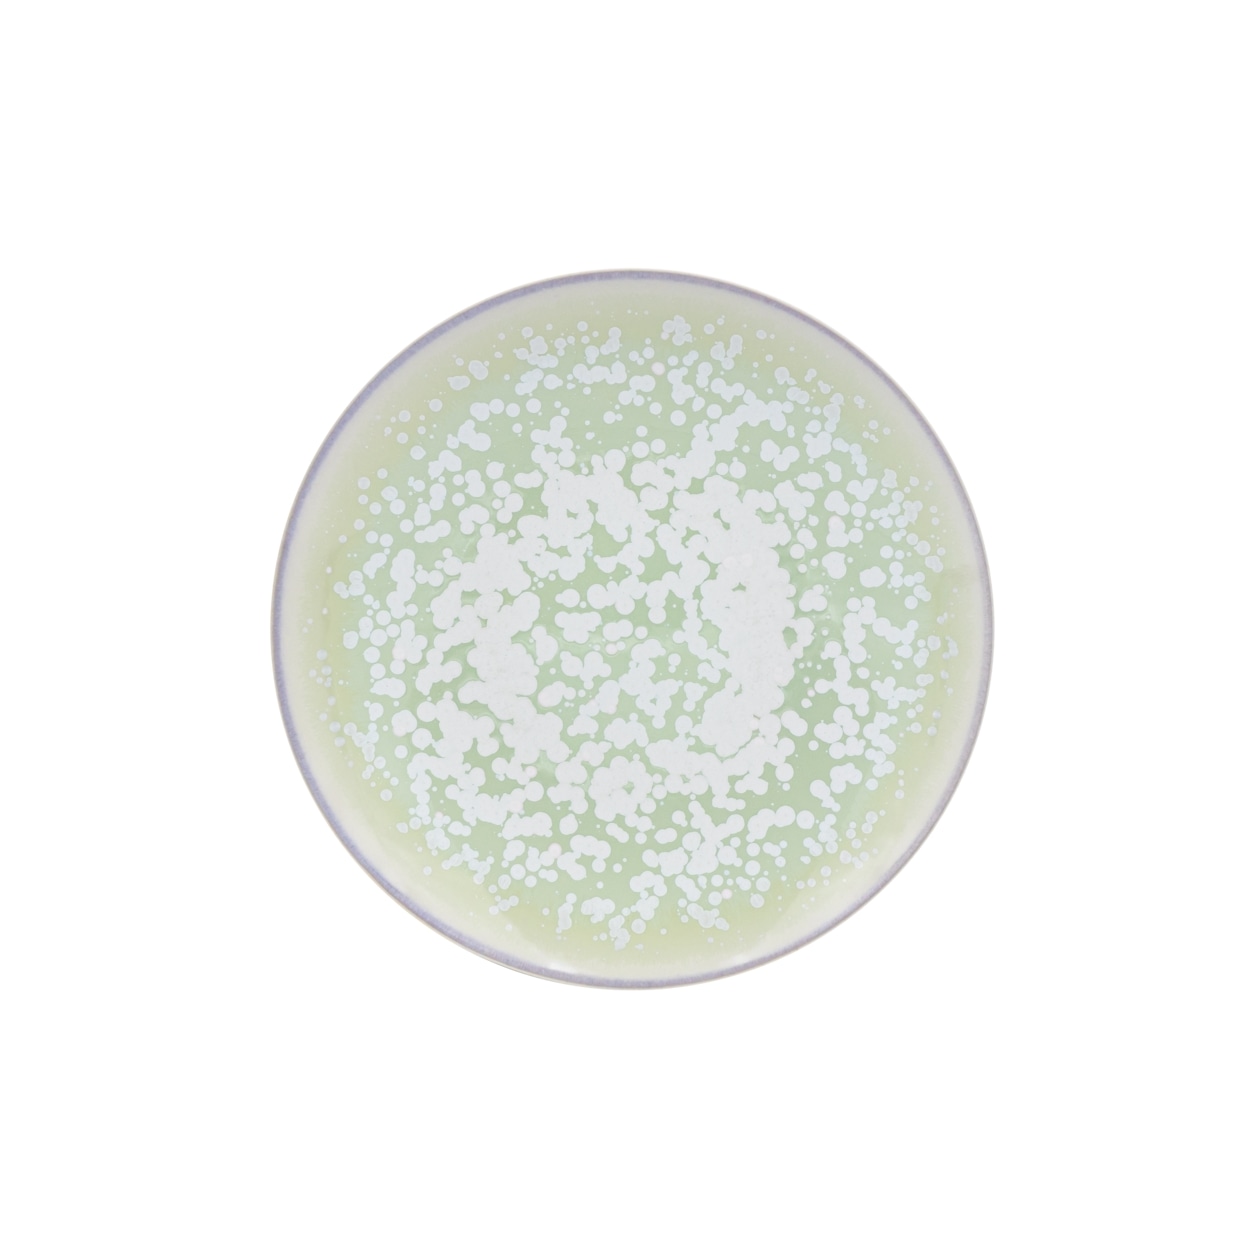
Jaune de Chrome, Song Amande, Dessert plate

Jaune de Chrome, Song Amande, Dessert plate
Immerse yourself in the refreshing ambiance of a gentle breeze with Jaune de Chrome's Song Amande dinnerware collection. This extraordinary collection exemplifies the mastery of glazing techniques as Jaune de Chrome adorns the exquisite Limoges porcelain from their sister manufacturer J.L Coquet. Elegant, dynamic, and truly enchanting, Jaune de Chrome's dinnerware will astonish and delight your guests with its mesmerizing glazing artistry. Diverging from traditional printing or painting methods, Jaune de Chrome's artisans skillfully spray-paint the raw porcelain with pigmented glazes, meticulously fired to perfection. The decor itself fuses with the glaze, creating surfaces that are flawlessly glossy, smooth, and resistant to scratches. This exceptional process ensures that the dinnerware not only possesses visual allure but also offers effortless maintenance. The Song Amande dinner service presents a carefully curated selection of popular J.L Coquet shapes. The glaze employed in this collection incorporates metallic pigments, lending an extra touch of luxury.